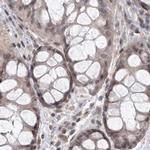
RAP80 Antibody in Immunohistochemistry (IHC)

Search
Invitrogen
RAP80 Polyclonal Antibody
{{$productOrderCtrl.translations['antibody.pdp.commerceCard.promotion.promotions']}}
{{$productOrderCtrl.translations['antibody.pdp.commerceCard.promotion.viewpromo']}}
{{$productOrderCtrl.translations['antibody.pdp.commerceCard.promotion.promocode']}}: {{promo.promoCode}} {{promo.promoTitle}} {{promo.promoDescription}}. {{$productOrderCtrl.translations['antibody.pdp.commerceCard.promotion.learnmore']}}

Please note: We are reviewing Western blot images included in the antibody testing data in our catalog, including those provided by third parties. Unless expressly labeled or annotated as “raw-unedited”, Western blot images included in the antibody testing data in our catalog may have been edited, optimized or otherwise adjusted for presentation.
产品信息
PA5-57978
种属反应
宿主/亚型
分类
类型
抗原
偶联物
形式
浓度
规格
纯化类型
保存液
内含物
保存条件
运输条件
RRID
产品详细信息
Immunogen sequence: PVFENVNVKS FDRCTGHSAE HTQCGKPQES TGRGSAFLKA VQGSGDTSRH CLPTLADAKG LQDTGGTVNY FWGIPFCPDG VDPNQYTKVI LCQLE
Highest antigen sequence identity to the following orthologs: Mouse - 84%, Rat - 81%.
靶标信息
RAP80 was initially identified as zinc-finger containing nuclear protein that is highly expressed in testis and interacts with the retinoid-related testis-associated receptor (RTR). Later experiments revealed that RAP80 is recruited by the Coiled-coil domain 98 (CCDC98) protein to the breast cancer-1 protein BRCA1, allowing the formation of BRCA1 foci in response to DNA damage caused by ionizing radiation. Both RAP80 and CCDC98 are required for DNA damage resistance, G2-M checkpoint control, and DNA repair. Cells depleted of either RAP80 or CCDC98 exhibited increased sensitivity to ionizing radiation, although not as much as in BRCA1-depleted cells, suggesting that RAP80 and CCDC98 control only part of the DNA damage response role of BRCA1. At least four isoforms of RAP80 are known to exist.
仅用于科研。不用于诊断过程。未经明确授权不得转售。
篇参考文献 (0)
生物信息学
蛋白别名: BRCA1-A complex subunit RAP80; Receptor-associated protein 80; Retinoid X receptor-interacting protein 110; Ubiquitin interaction motif-containing protein 1
基因别名: RAP80; RXRIP110; UIMC1
Entrez Gene ID: (Human) 51720




